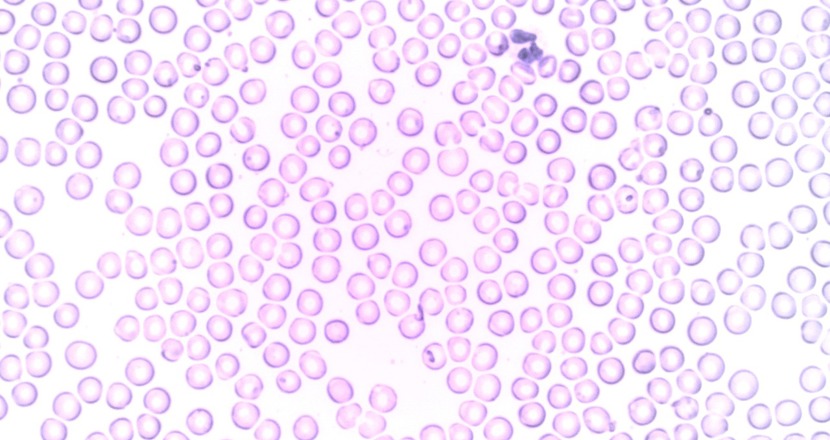
Mikroskopbild på blodceller. Foto.

Immunceller hos ALS-patienter kan förutsäga sjukdomsförloppet
 Genom att mäta immunceller i ryggmärgsvätskan vid diagnostiseringen av ALS går det att förutsäga hur snabbt sjukdomsförloppet kommer att gå, enligt en studie från Karolinska Institutet som publicerats i Nature Communications.
Genom att mäta immunceller i ryggmärgsvätskan vid diagnostiseringen av ALS går det att förutsäga hur snabbt sjukdomsförloppet kommer att gå, enligt en studie från Karolinska Institutet som publicerats i Nature Communications.
Forskarna i studien samlade in färskt blod och ryggmärgsvätska från 89 patienter i Stockholm som nyligen hade diagnostiserats med ALS mellan mars 2016 och mars 2020 och de följdes till och med oktober 2020.
Olika T-celler är inblandade
Studien visar att en hög andel av så kallade effektor-T-celler är associerad med en låg överlevnadsgrad. Samtidigt visar studien att en hög andel av aktiverade regulatoriska T-celler är skyddande mot sjukdomen. Fynden ger nya evidens för T-cellers inblandning i sjukdomsförloppet och visar att vissa typer av effektor-T-celler ansamlas i ryggmärgsvätskan hos ALS-patienter.
– Studien kan bidra till utvecklingen av nya behandlingar som riktar in sig på immunceller för att sakta ned sjukdomsförloppet, säger doktoranden och försteförfattaren Solmaz Yazdani till sajten neurologiisverige.se
Nästa steg i hennes forskning är att studera hur T-celler bidrar till sjukdomsförloppet.